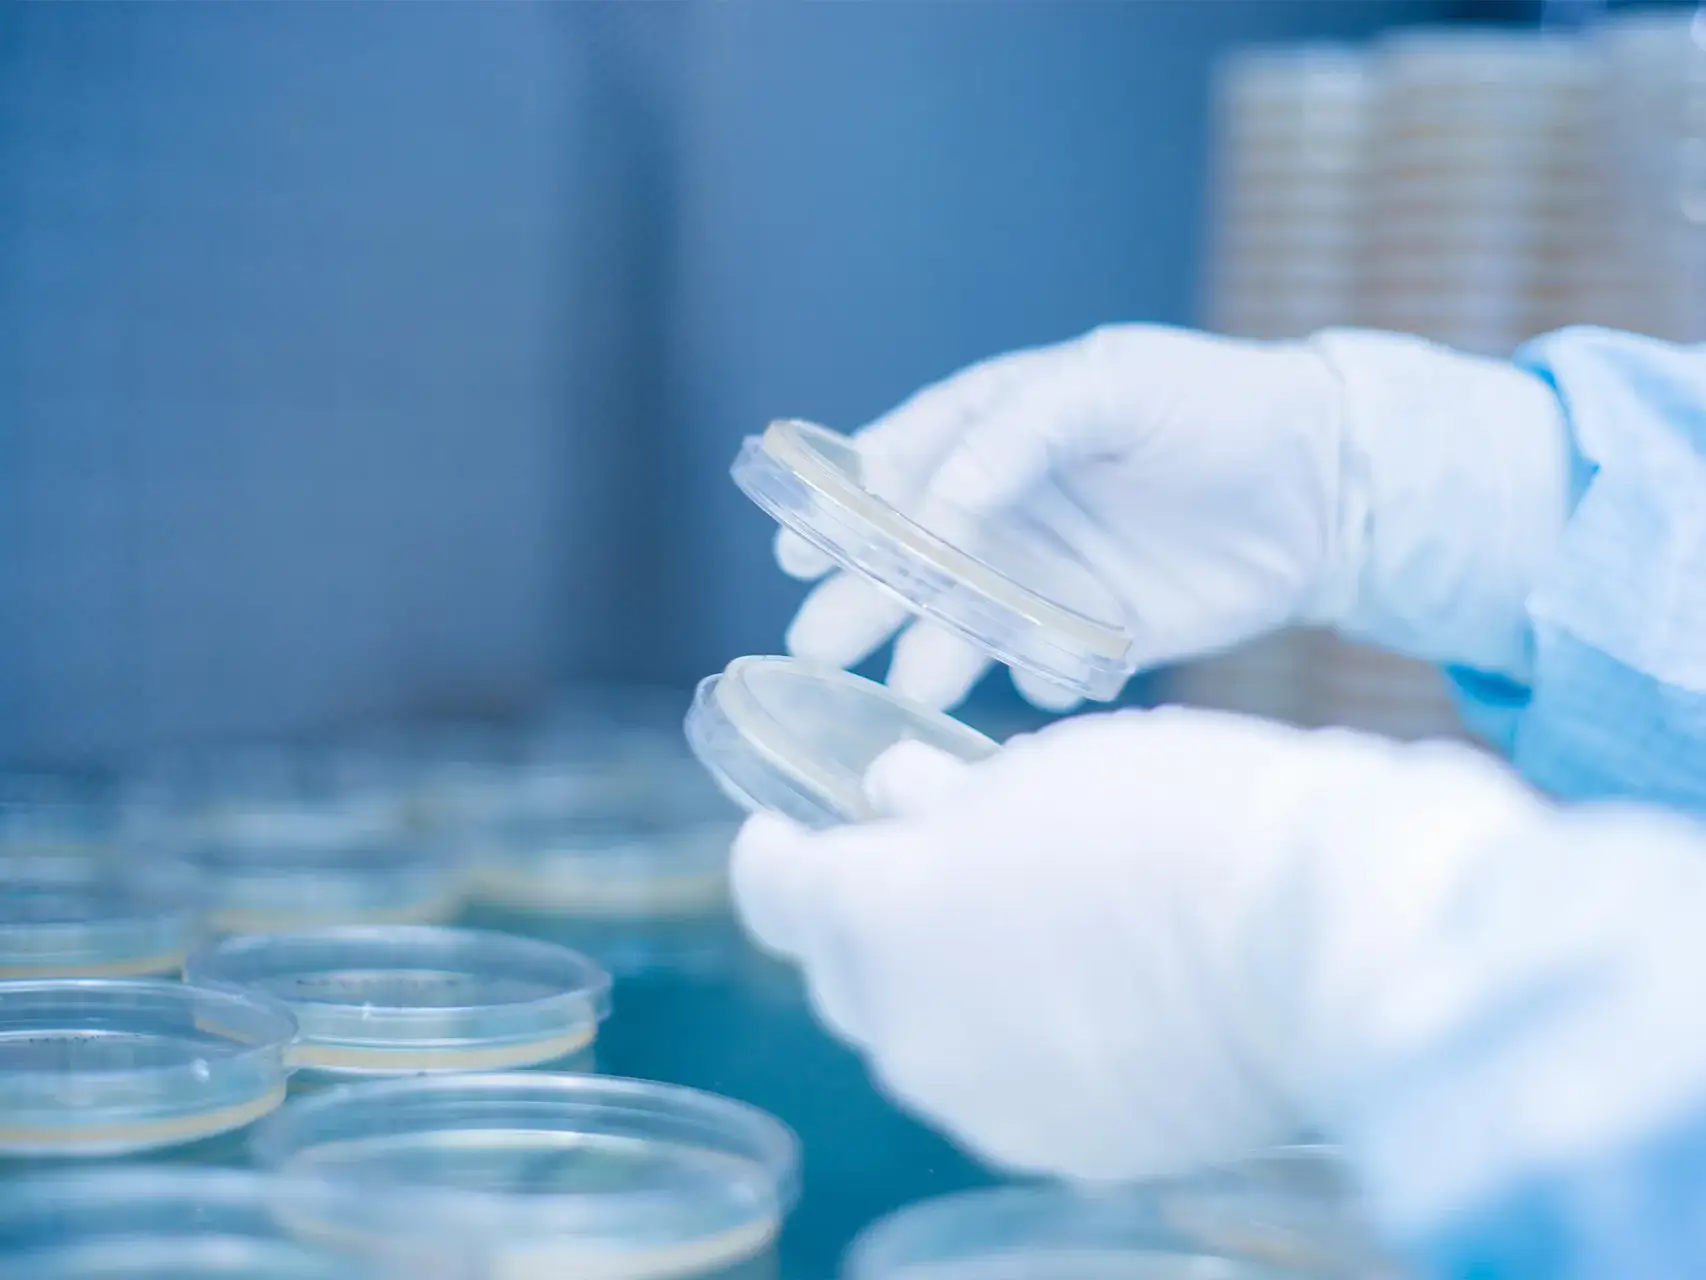

Nuestros productos
Fabricamos y distribuimos productos para el control de contaminación en cuartos limpios y áreas asépticas.

Servicios especializados
Contamos con servicios que cumplen las normas internacionales y podemos validar y certificar de acuerdo a la ISO 14644-1.

Atención a cliente
Contamos con asesores dispuestos a resolver sus dudas y brindar una cotización que se ajusten a las necesidades de su empresa.
Brindamos soluciones, calidad y esterilidad desde 1988
Tenemos la firme convicción de que la calidad se logra con la constante capacitación y cuidando de que todas nuestras actividades se hagan de acuerdo a procedimientos y controles de calidad.
Exportamos productos mexicanos de calidad mundial
Para una cotización a medida, contáctanos y uno de nuestros ejecutivos te apoyará.
Teléfono: (55) 5816-5878















